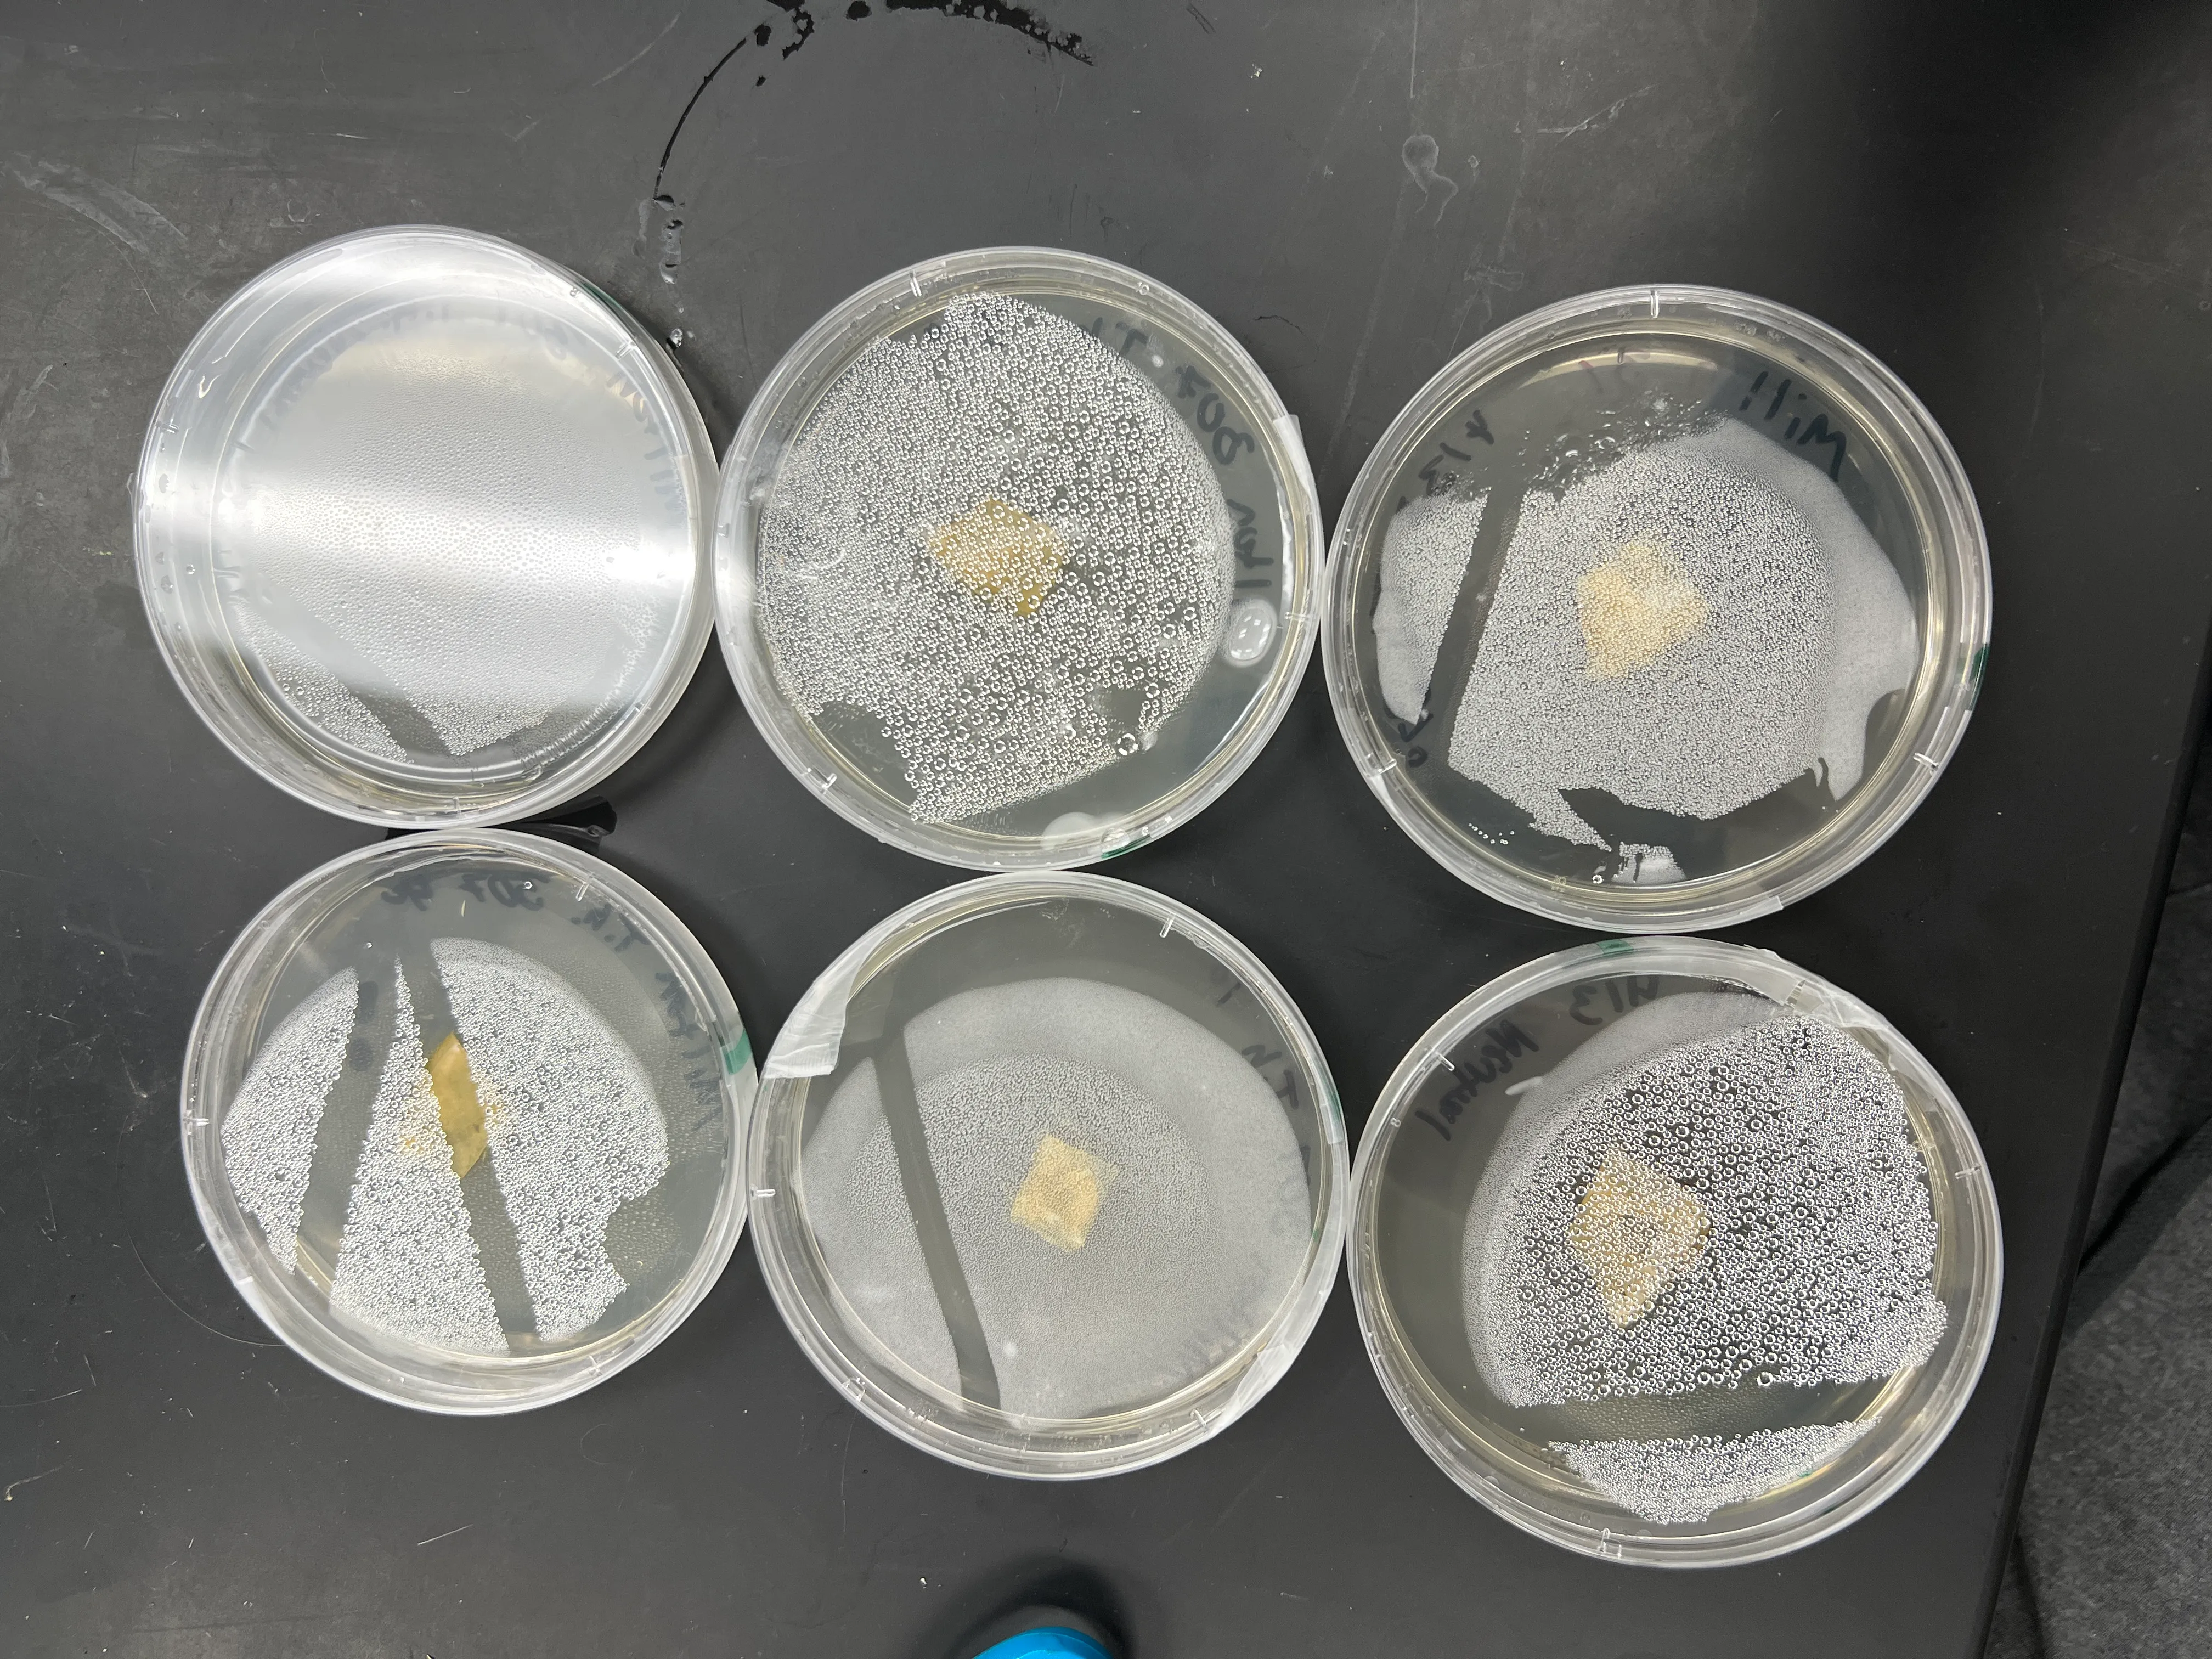
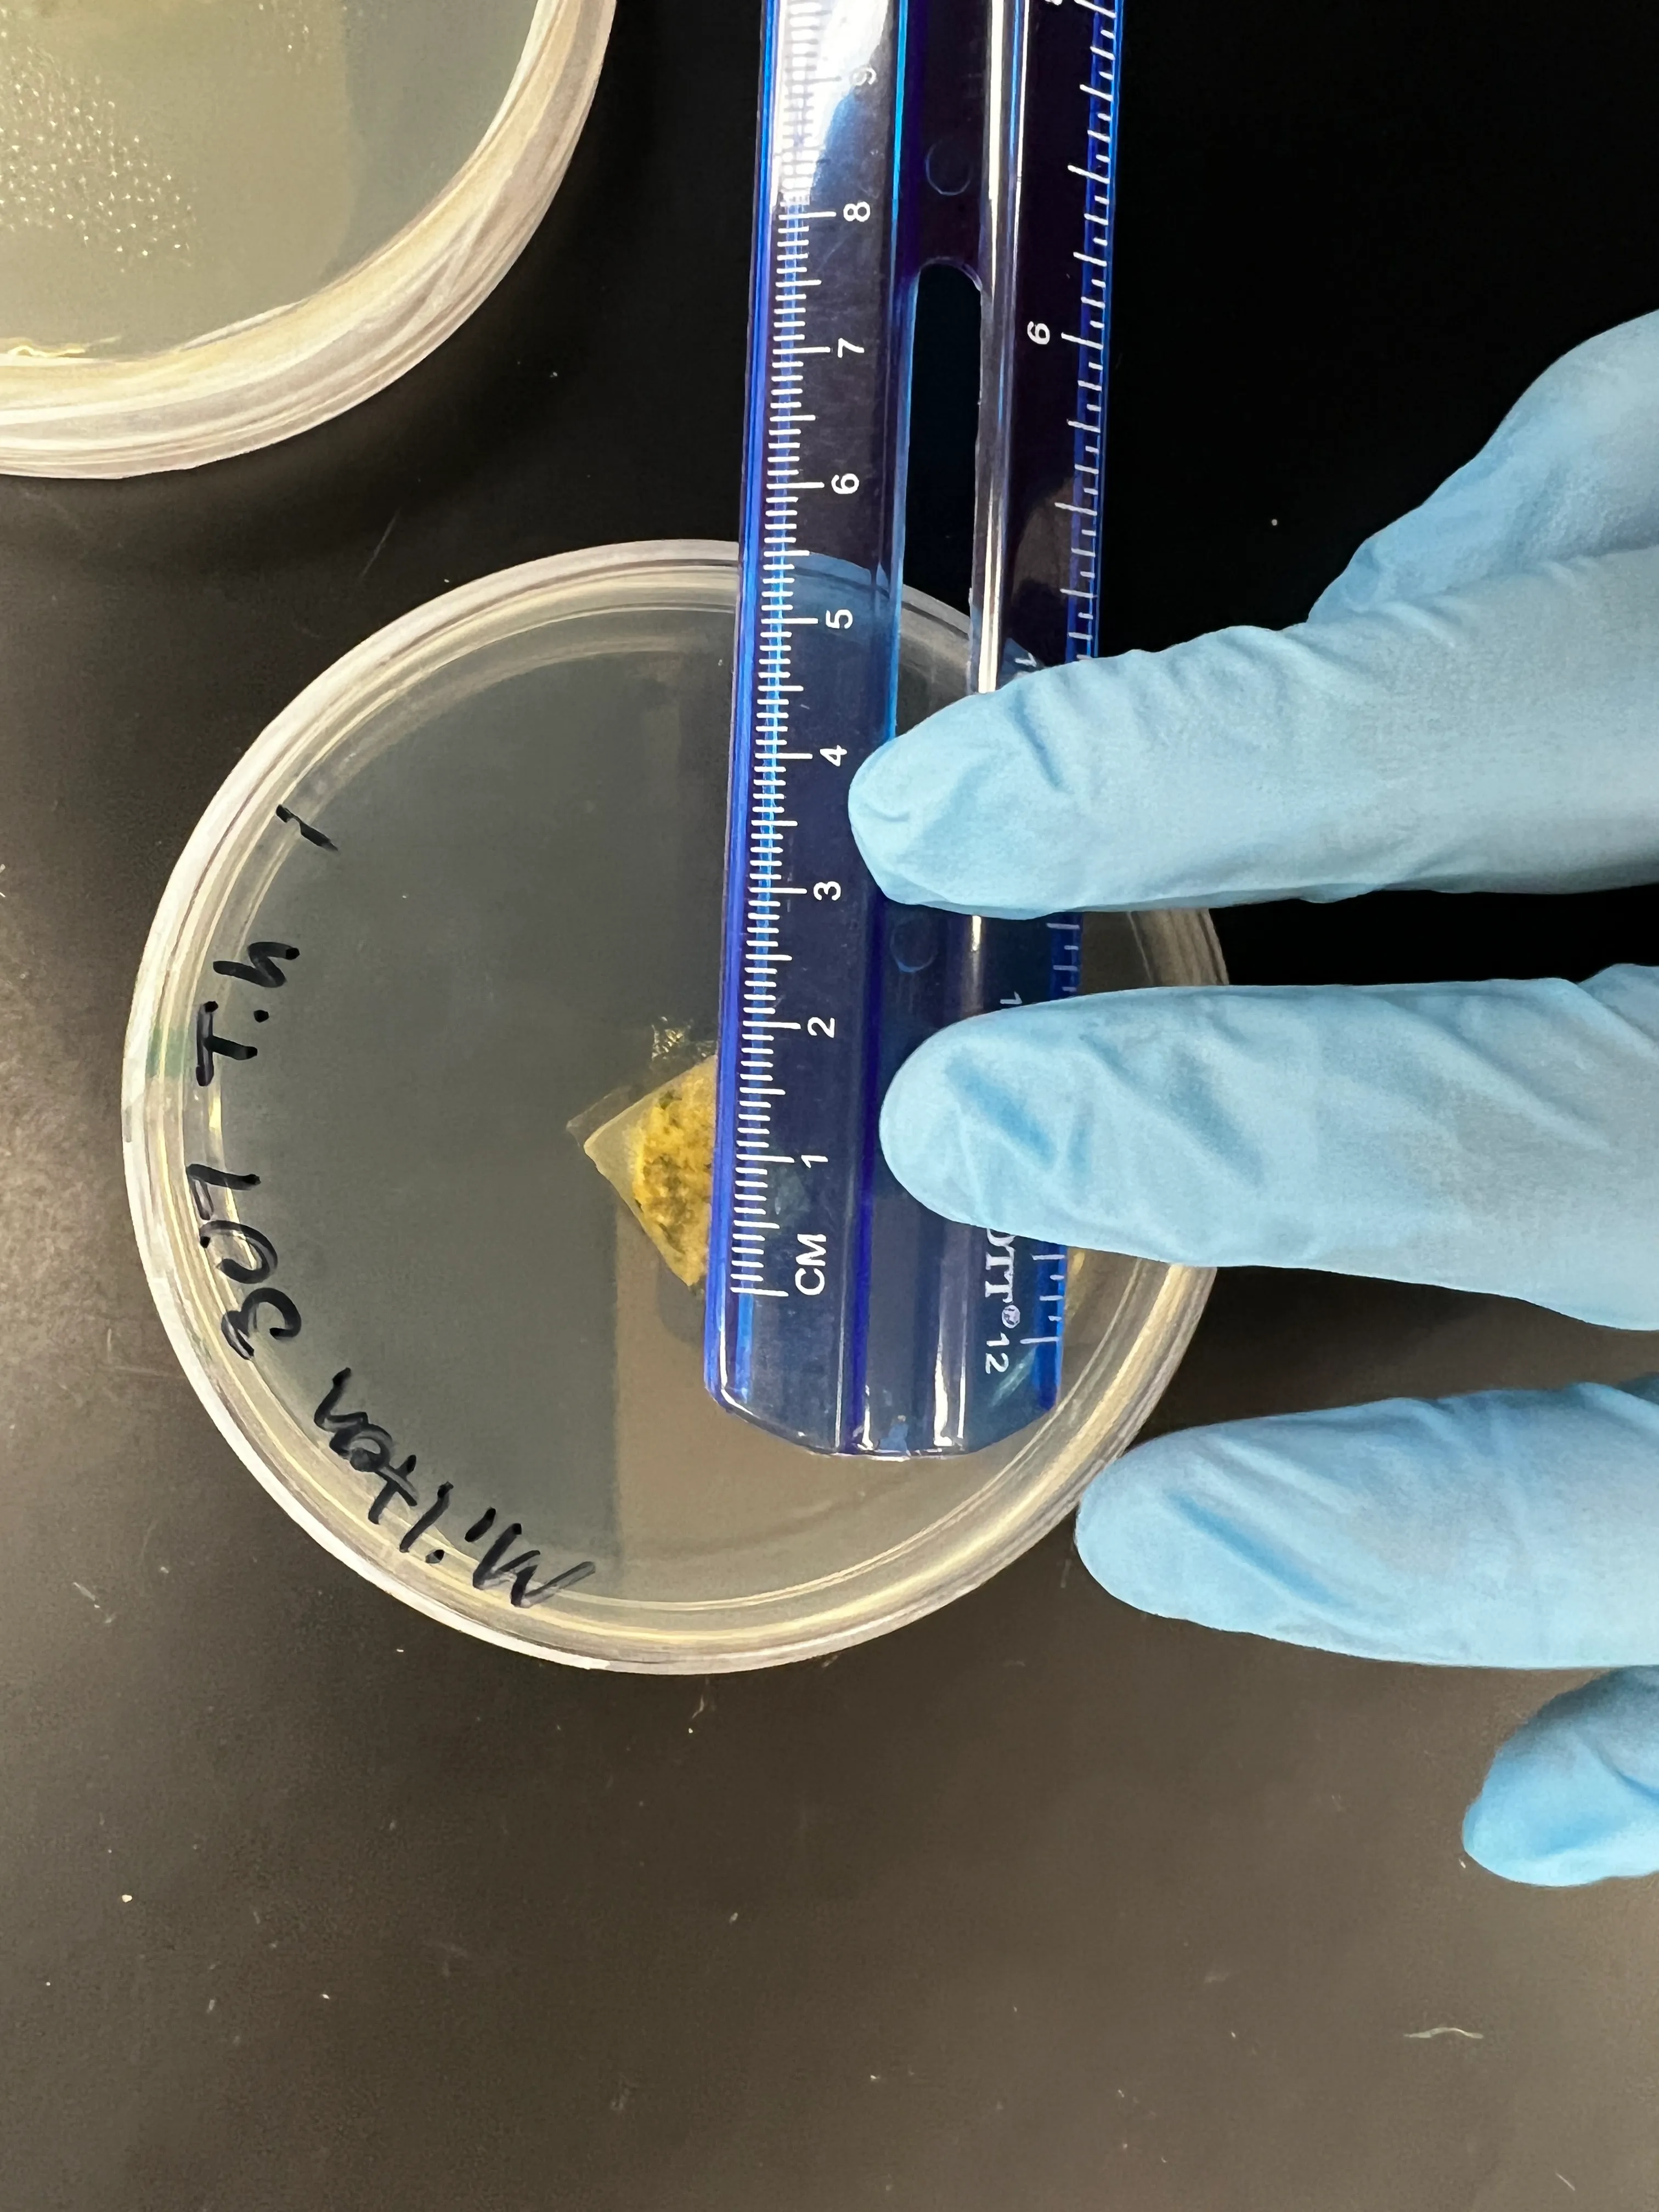
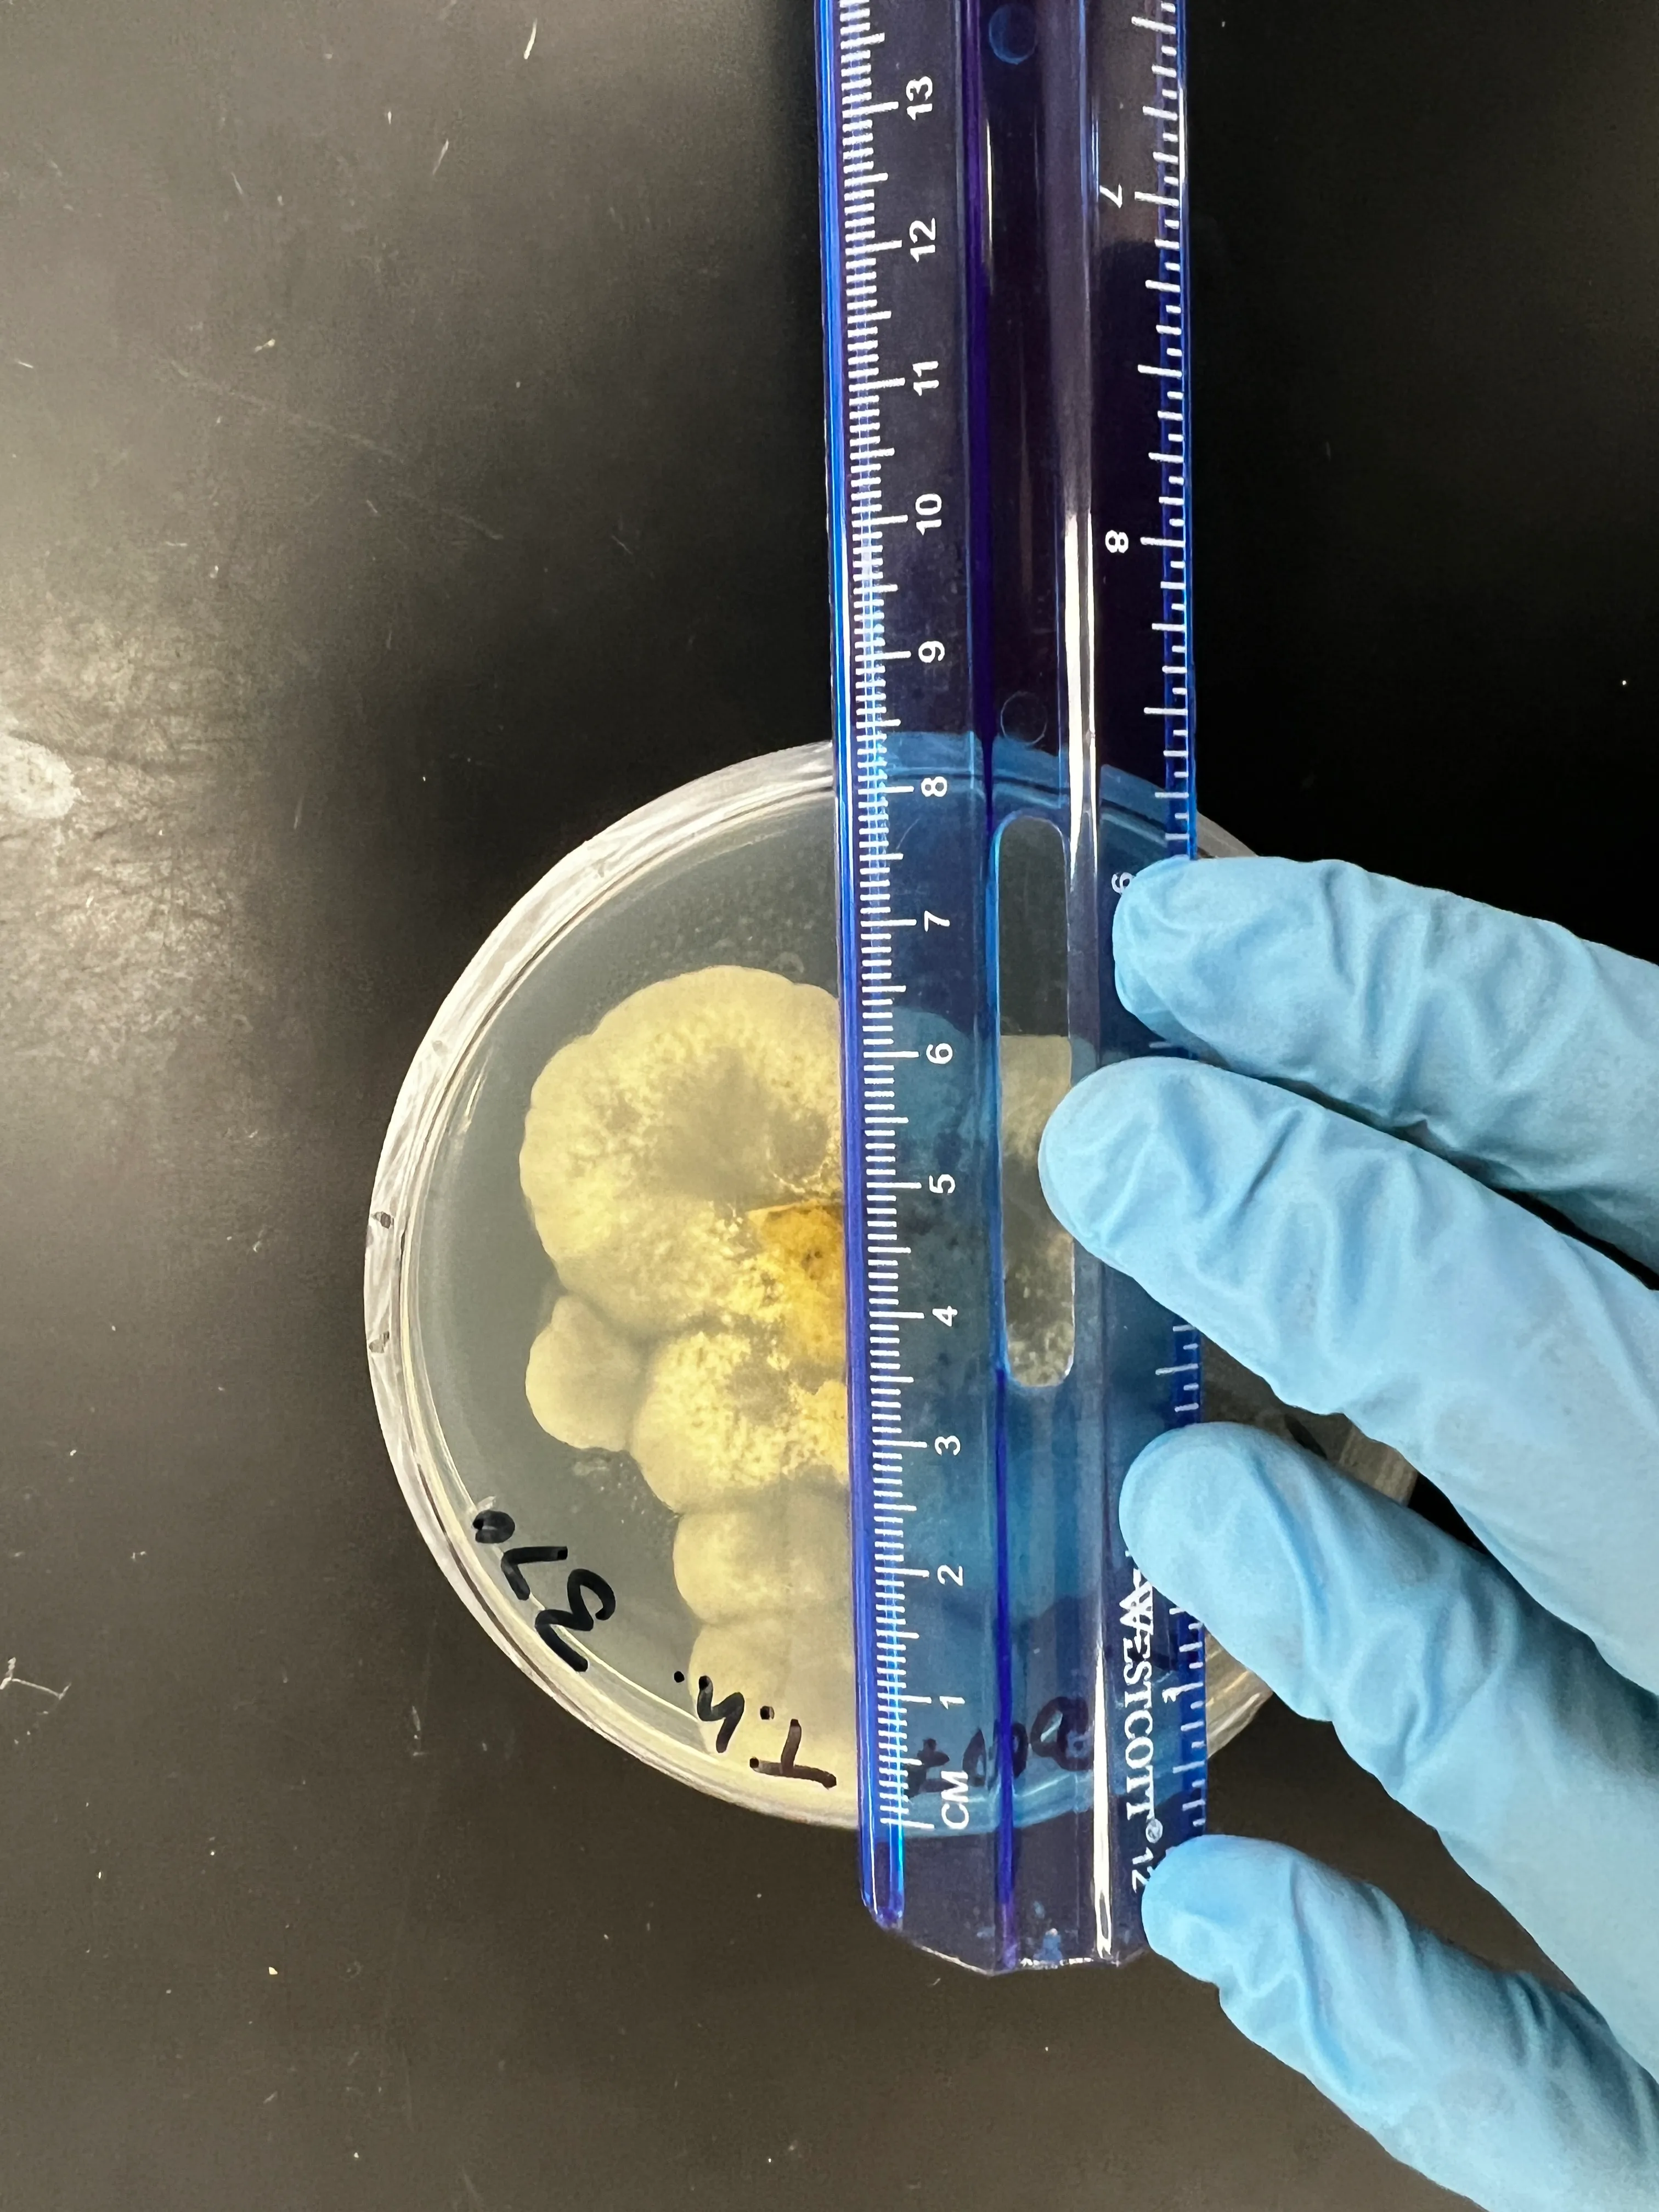
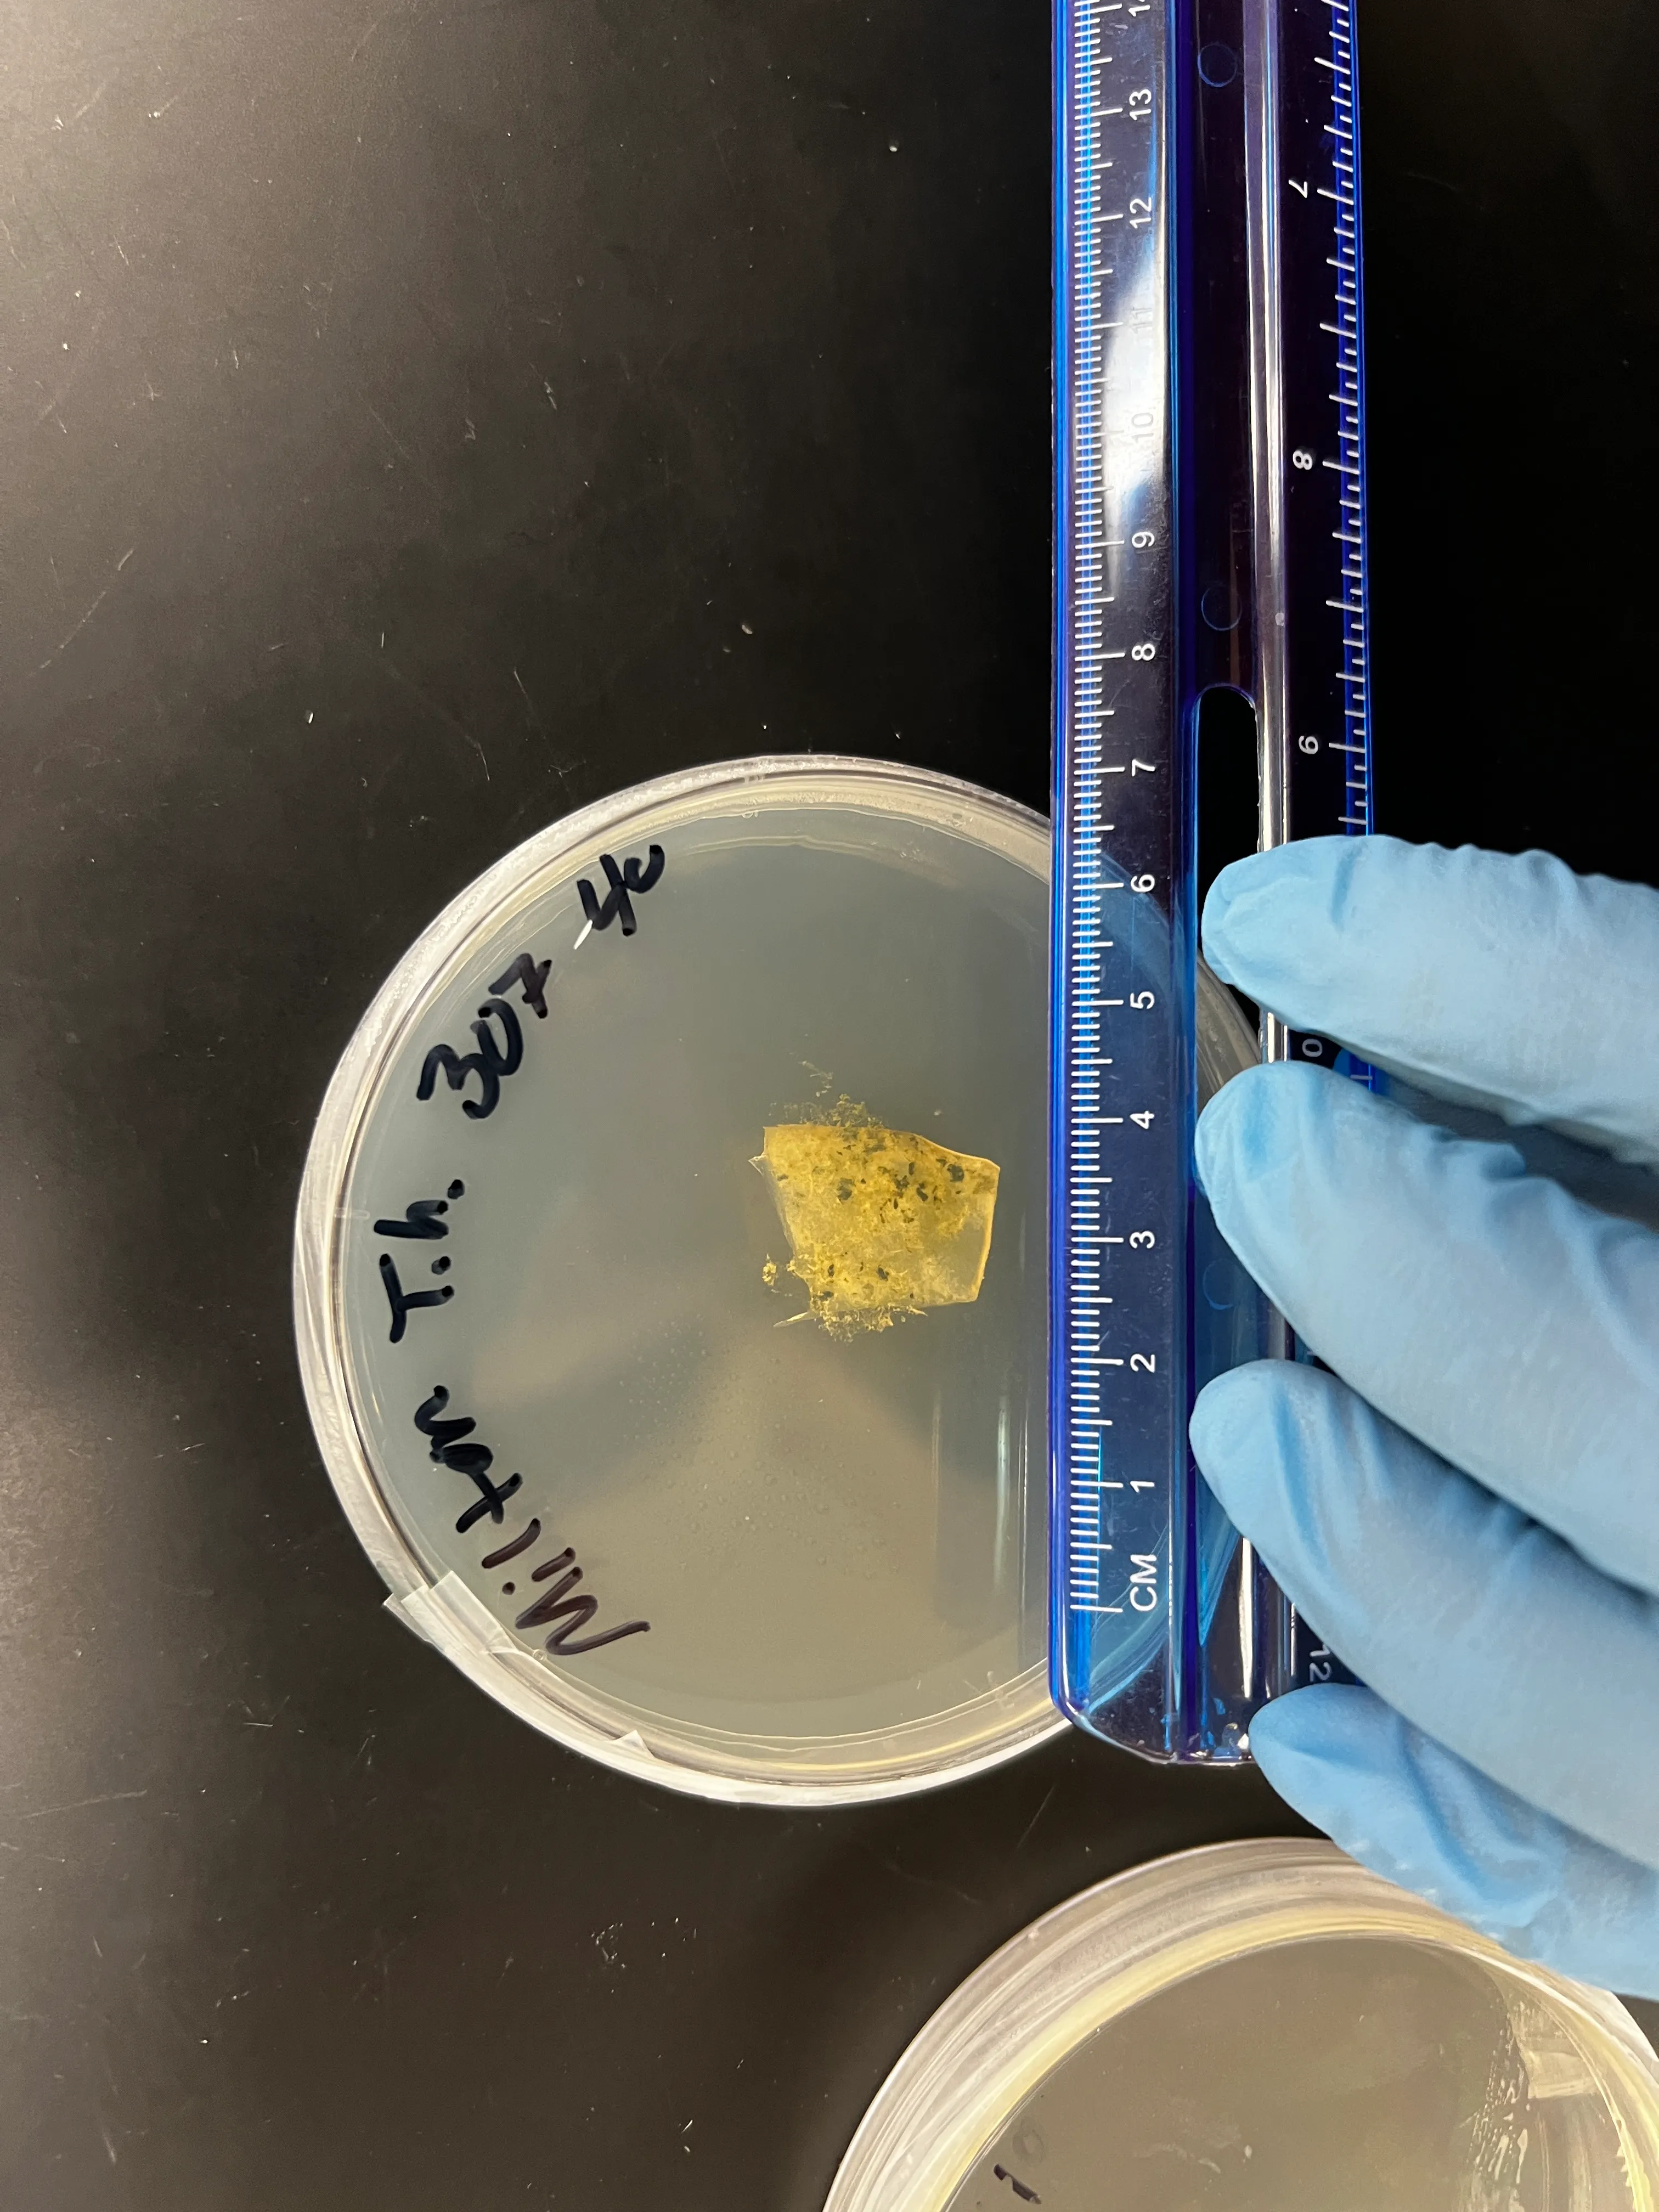
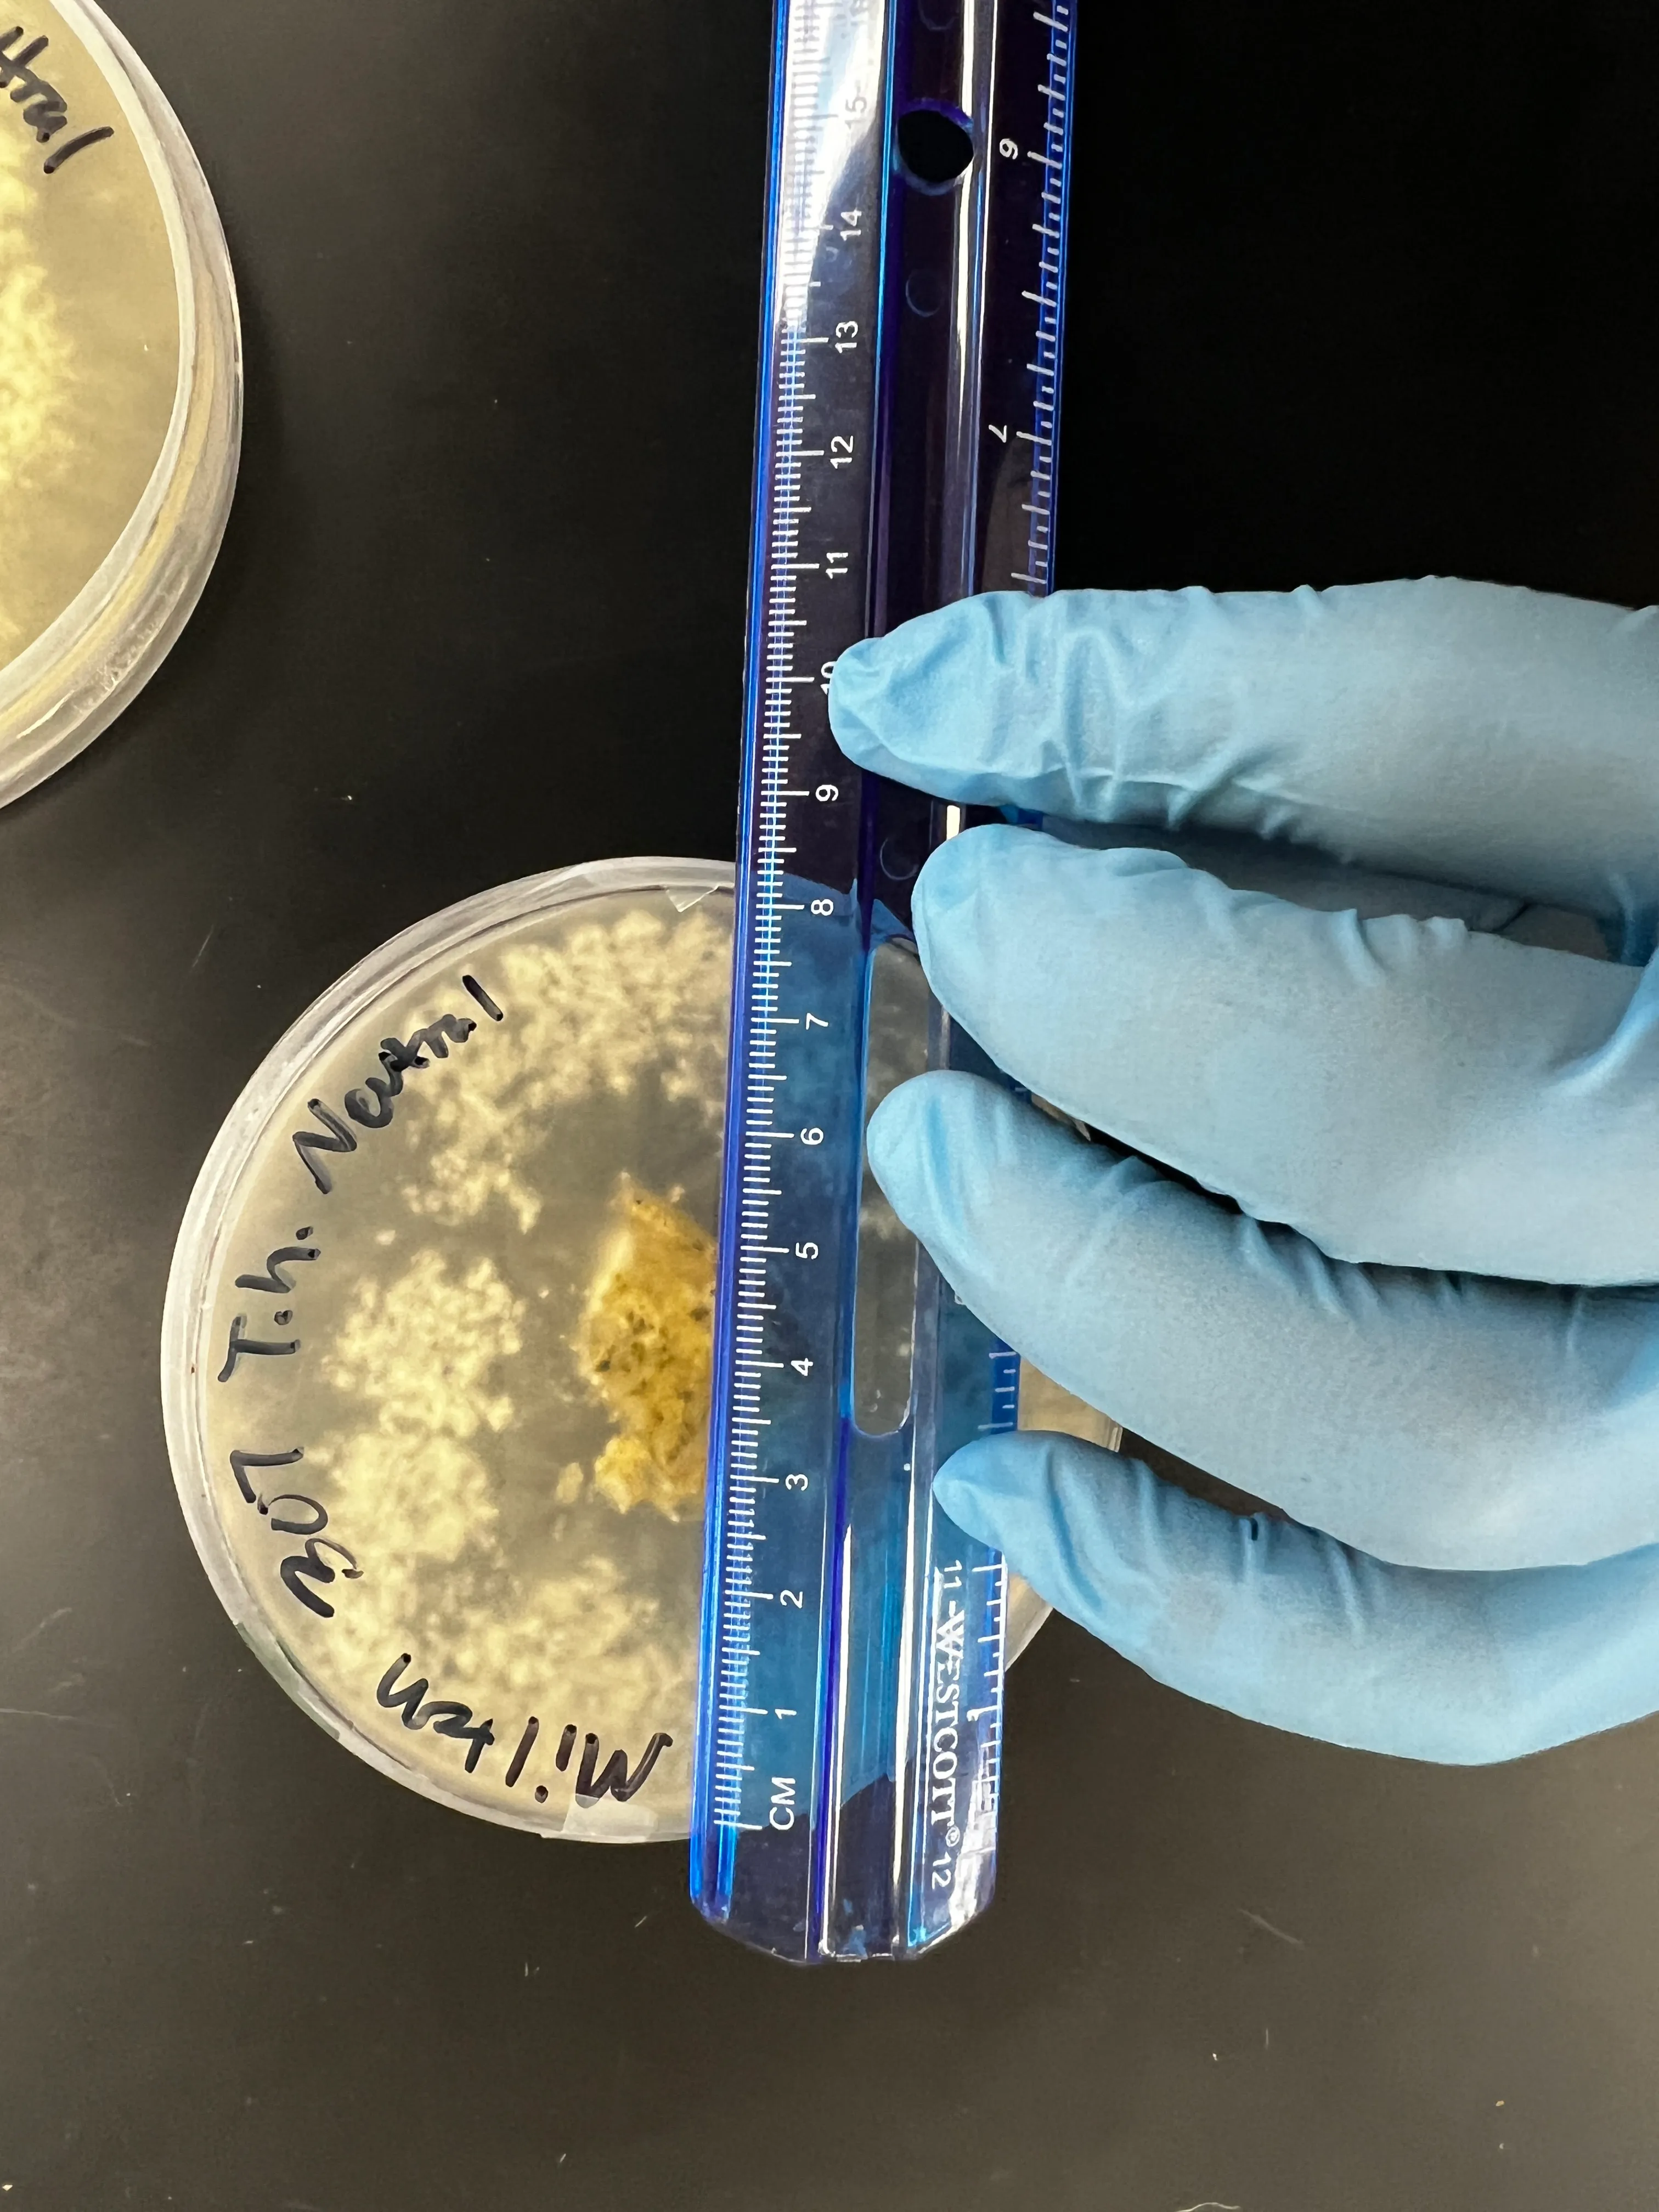
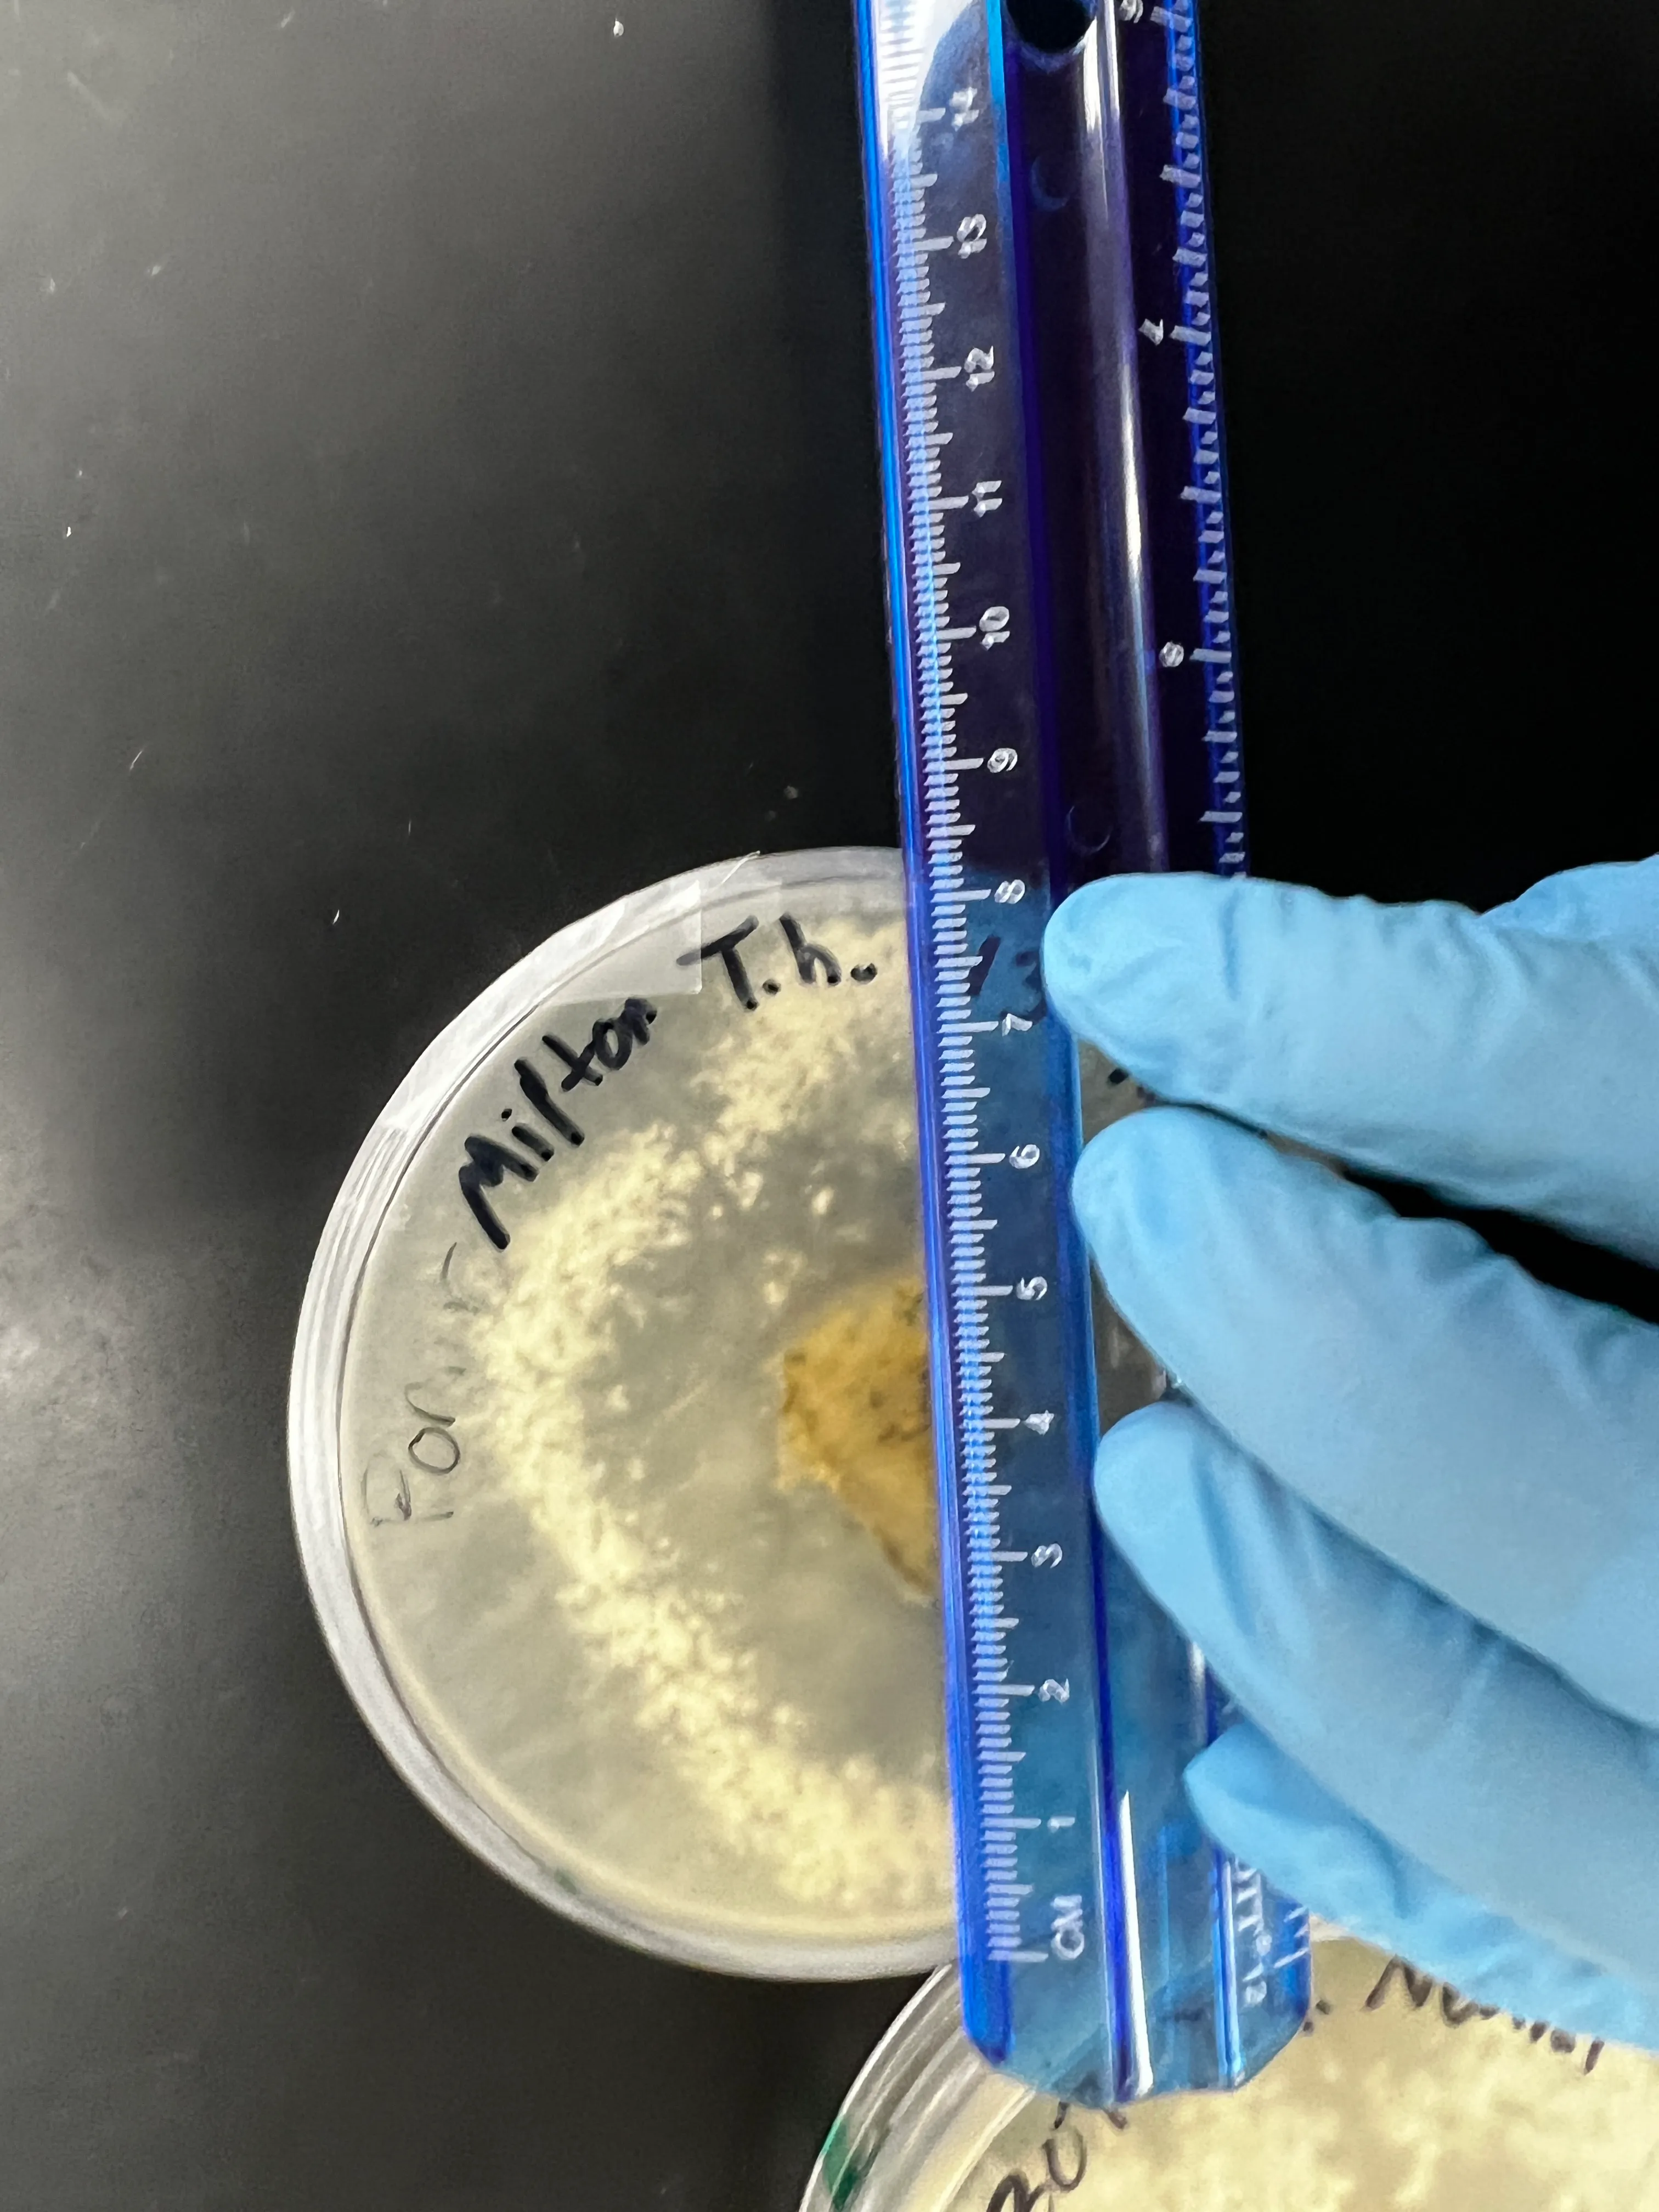

Experiment #1: Growth of Trichoderma harzianum at different temperature.
Hypothesis: Raising ambient temperature will increase the growth rate of Trichoderma harzianum due to its preference for warm conditions.
Experiment
Prepare 6 Petri dishes. For this experiment, I used Nutrient Agar (NA) plates because it was what my lab had available. In each of the dishes, take a sample from a pure culture of Trichoderma harzianum and place it in the new dishes. Do your best to keep the samples around the same area for more consistent results.
Control
For this experiment, I’ll grow T. harzianum at room temperature (~21 °C) because it is the temperature at which I usually keep my cultures at. I will also use this temperature as a control for the other two treatments.
Treatments
- 4 °C (fridge)
- 37 °C (incubator)
I placed 2 dishes in each of the three environments. I made sure to label the dishes so I could keep track of which was which.
My prepared petri dishes
My prepared petri dishes
I placed 2 dishes in the fridge at 4 °C, 2 dishes in the lab at room temperature (~21 °C), and 2 dishes in an incubator at 37 °C. I made sure to label the dishes so I could keep track of which was which.
I left this petri dishes to grow for 4 days. After a week, T. harzianum can already reach the edge in some cases, so I thought it would be best to take results before then. Results were recorded by measuring the diameter of the colony in millimeters. I took two measurements per dish and averaged them.
Results
| Temperature | Growth (mm) |
|---|---|
| 4 °C | 16 (no growth) |
| 4 °C | 18 (no growth) |
| ~21 °C (room temperature) | 85 (whole dish) |
| ~21 °C (room temperature) | 85 (whole dish) |
| 37 °C | 62 |
| 37 °C | 75 |
Images
4 °C
|  |
~21 °C
| |
37 °C
| |
Conclusion
The results of this experiment were not what I expected. I thought that T. harzianum would grow best at 37 °C, but it actually grew best at room temperature. The growth at 4 °C was almost non-existent, which is what I expected. 37 °C was past the optimal temperature for T. harzianum.
I think that the results of this experiment are consistent with the hypothesis, but I would like to repeat it with a larger sample size and more temperature points. I would also like to try using different media, such as potato dextrose agar (PDA) to see if that has an effect on the growth rate.